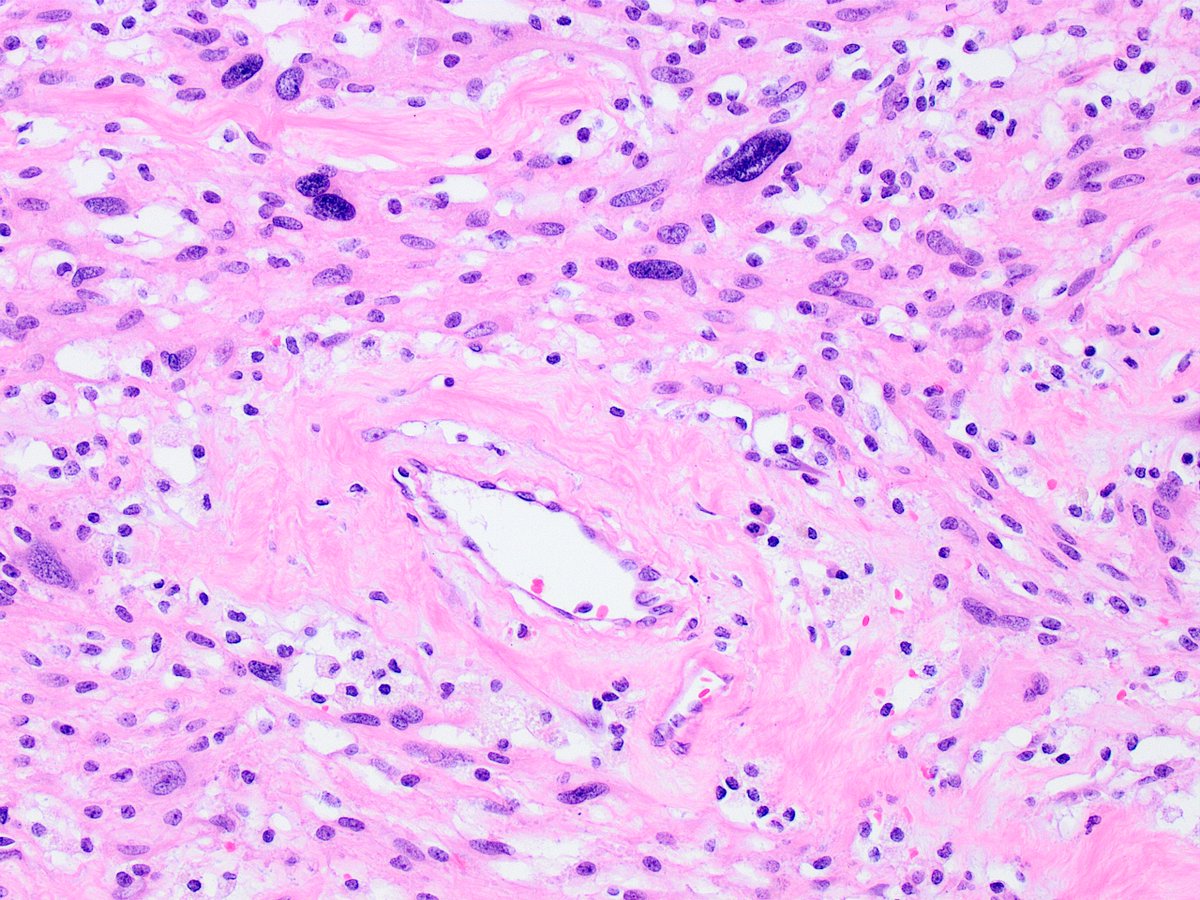
Kiril_T_Can's tweet image. Received as "left adrenal and tumor". First photo, "adrenal" (top), "tumor" (bottom). Remaining photos are from the tumor (11 cm greatest dimension, grew over several years). 
🤔🔬

MondorPath
@MondorPath
Département de Pathologie de l'Hôpital Henri Mondor
You might like
Hi #pathologists, have you realized how effortlessly you can navigate through your image management system and store digital slides in your private virtual slidebox? Securely share cases with your collaborators and experience #DigitalPathology like never before.#WSI #PathTwitter
Don't get fooled by reactive mesothelial cells and histiocytes! @Sara_Jiang #cytopath #CAPVirtualPath




Reports From the @IntSocUropath Consultation Conference on Molecular Pathology of Urogenital Cancers are available prostate journals.lww.com/ajsp/Abstract/… Bladder journals.lww.com/ajsp/Abstract/… Kidney journals.lww.com/ajsp/Abstract/… Testis journals.lww.com/ajsp/Abstract/… Penile cancer journals.lww.com/ajsp/Abstract/…
Hematopathology!! 🥰. Today’s CAP rapid 🔥 board review. I can’t wait to do a rotation and fellowship in Hempath! Thank you @KMirza for this lecture! #CAPVirtualPath #pathology #hempath



#FNAFriday Low Grade Mucoepidermoid carcinoma in the parotid gland. ▫most common malignancy ▫mucin-filled cystic lesion ▫mucinous, intermediate and squamoid cells ▫bland-looking nuclei ▫DDx: Warthin or Pleomorphic Adenoma w squamous/mucinous metaplasia #ENTPath #CellBlock




Join me for #capvirtualpath lecture tomorrow! What is controversial in #prostatecancer to you? @Pathologists


Received as "left adrenal and tumor". First photo, "adrenal" (top), "tumor" (bottom). Remaining photos are from the tumor (11 cm greatest dimension, grew over several years). 🤔🔬

Renal tumor. Guess the stain and diagnosis. I will add some other H&E pictures @MondorPath #GUpath




Any idea ? Exsudative pleural effusion in a farmer. Dense polymorphic infiltrate, many eosinophils, focal necrosis...and an unindentified guest !! Help !! #pathology #infectiousdisease




Thyroid H and E and beta-catenin. Decided this young patient needs a colonoscopy.


FH deficient renal cell carcinoma




SDH deficient renal cell carcinoma




"Renal tumors associated with hereditary predispositions in 2019" by @VerkarreVirgin2 Dr Virginie Verkarre At #CarrefourPathologie2019




"Classification of renal tumors : diagnostic algorithms" by Dr Sophie Ferlicot




Un #algorithme diagnostique efficace pour les tumeurs du #rein par Sophie Ferlicot #carrefourpathologie2019


Quand le #pathologiste joue un rôle clef dans l'identification des syndromes de prédisposition héréditaire aus tumeurs du #rein #carrefourpathologie2019




🇫🇷 Femme de 44 ans. Nodule unique du lobe droit de 1,7 cm. Macro : encapsulé et beige. Diagnostic ? 🇬🇧 44 yo woman. Single nodule of the right lobe of 1.7 cm. Gross: encapsulated and beige. Diagnosis ? @Elsevierconnect #francophonepath, #thyroid, #entpath, #endopath



United States Trends
- 1. $GHOST N/A
- 2. DataHaven Testnet N/A
- 3. Peralta N/A
- 4. Brewers N/A
- 5. Cyraxx N/A
- 6. Wawrinka N/A
- 7. Mets N/A
- 8. Hathaway N/A
- 9. #TusksUp N/A
- 10. Fredo N/A
- 11. Sproat N/A
- 12. #AEWDynamite N/A
- 13. Jett N/A
- 14. Alijah Arenas N/A
- 15. #ArknightsEndfield N/A
- 16. SDSU N/A
- 17. Myers N/A
- 18. Aztecs N/A
- 19. Cuomo N/A
- 20. Tennis N/A
You might like
Something went wrong.
Something went wrong.


































































































































